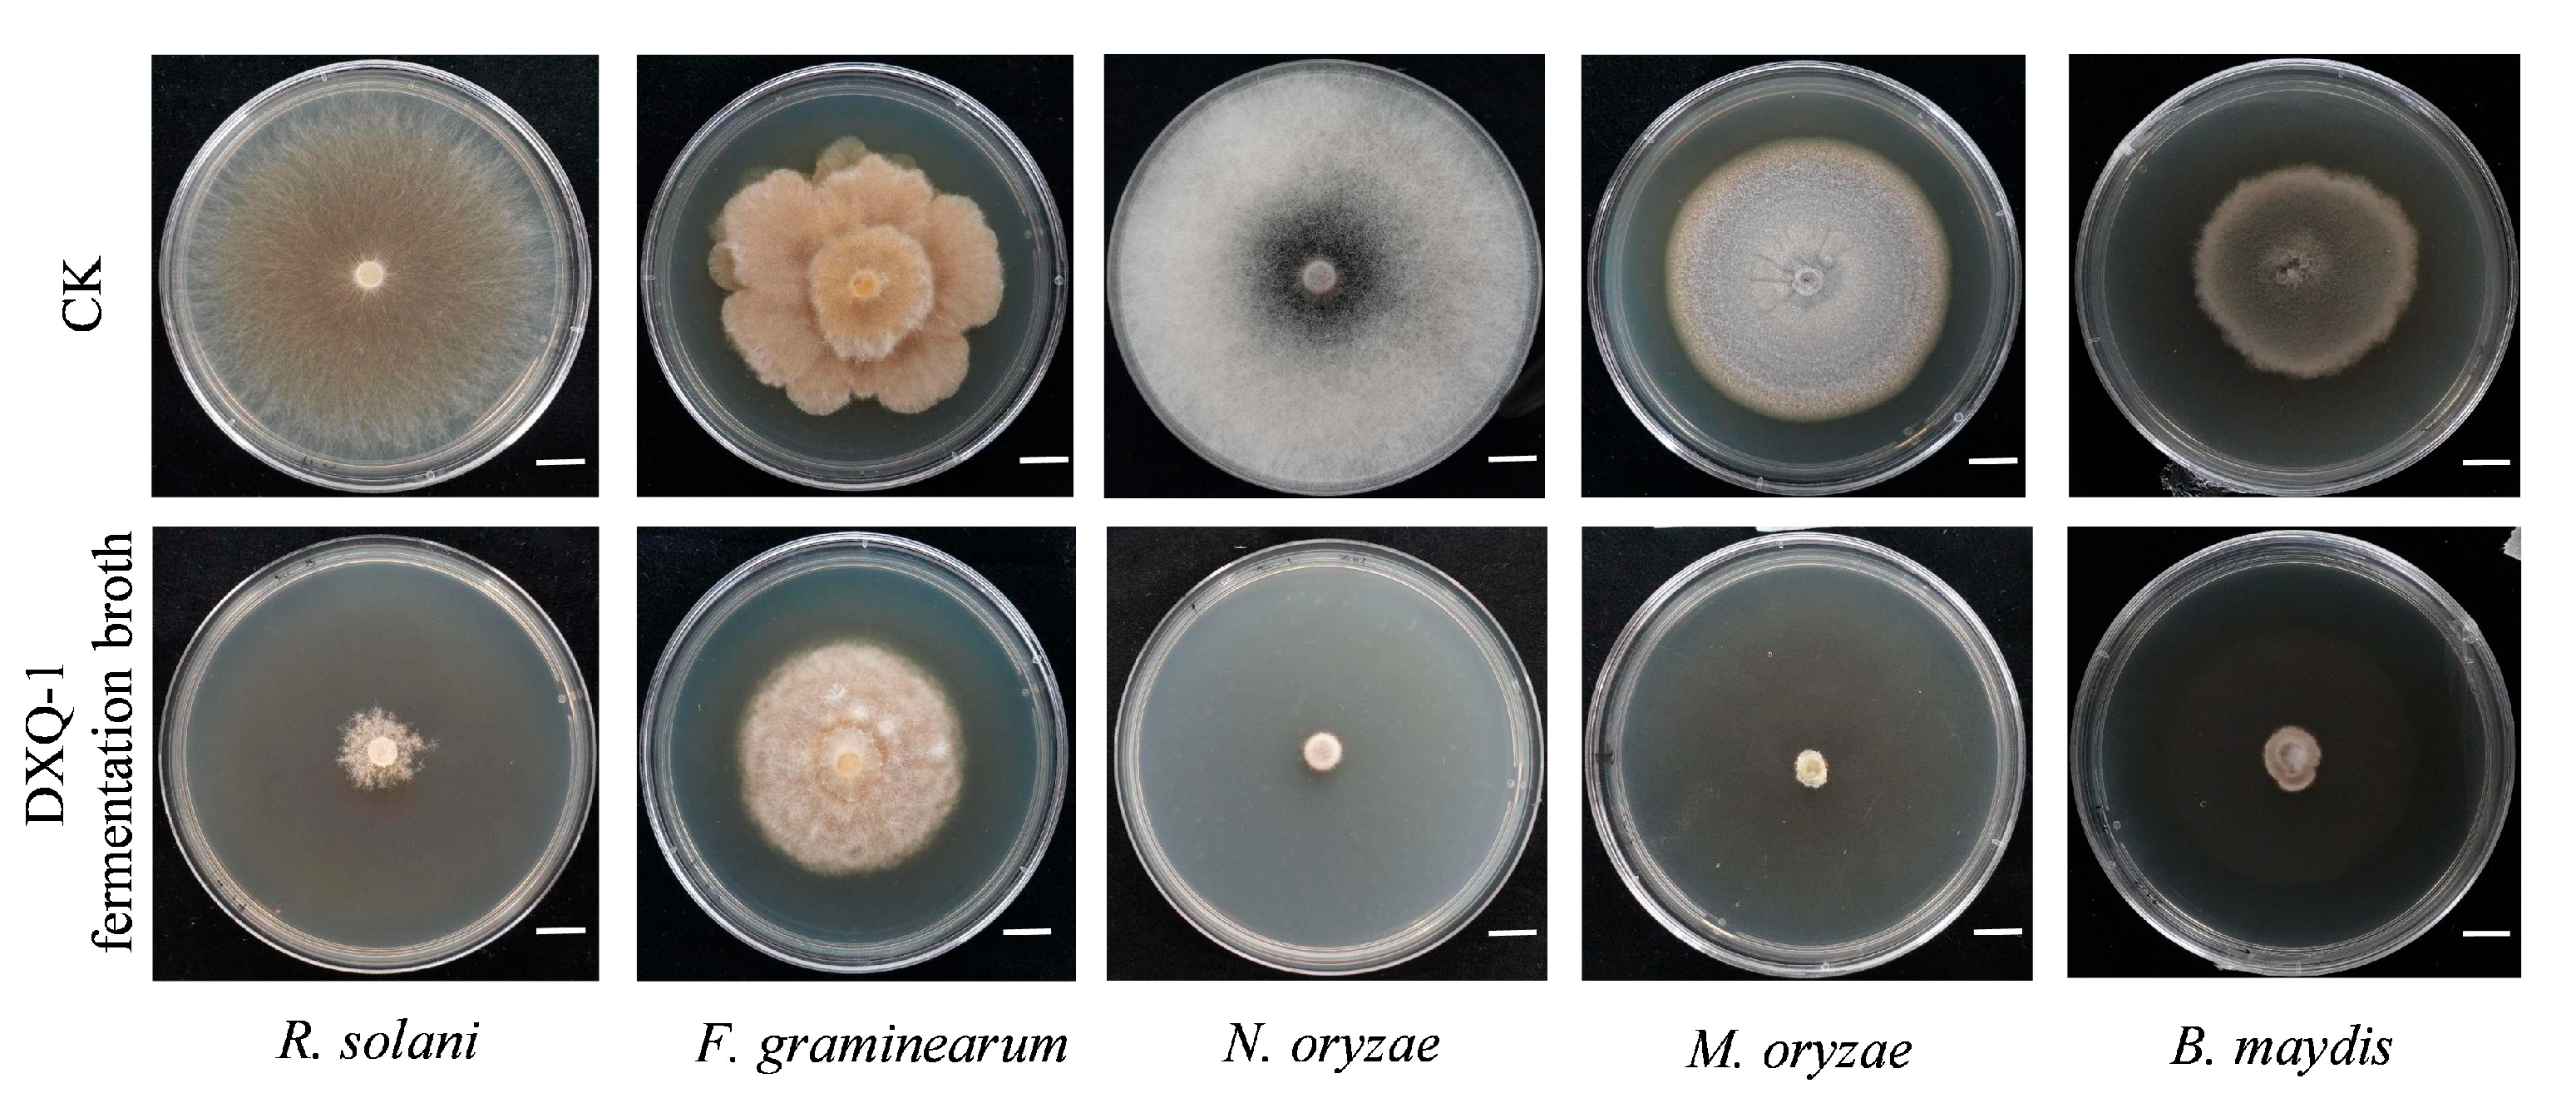
Microorganisms 13 01538 g005

Biocontrol Potential of Bacillus stercoris Strain DXQ-1 Against Rice Blast Fungus Guy11
Abstract
1. Introduction
2. Materials and Methods
2.1. Isolation and Identification of DXQ-1
2.2. Antifungal Activity and Pathogen Infection Experiments
2.3. Optimization of Fermentation Conditions for Strain DXQ-1
2.4. Isolation of Antifungal Active Substances
2.5. Growth-Promoting Ability Test of DXQ-1
2.6. Statistical Analysis
3. Results
3.1. Identification and Characteristics of the Bacillus stercoris Strain DXQ-1
3.2. Antagonistic Activity of the Biocontrol Bacterium B. stercoris Strain DXQ-1
3.3. Active Antimicrobial Substance Analysis of the Strain
3.4. Evaluation of the Growth-Promoting Effect of Strain DXQ-1
4. Discussion
5. Conclusions
Supplementary Materials
Author Contributions
Funding
Institutional Review Board Statement
Informed Consent Statement
Data Availability Statement
Conflicts of Interest
References
- Wang, S.Y.; Herrera-Balandrano, D.D.; Wang, Y.X.; Shi, X.C.; Chen, X.; Jin, Y.; Liu, F.Q.; Laborda, P. Biocontrol ability of the Bacillus amyloliquefaciens Group, B. amyloliquefaciens, B. velezensis, B. nakamurai, and B. siamensis, for the Management of Fungal Postharvest Diseases: A Review. J. Agric. Food Chem. 2022, 70, 6591–6616. [Google Scholar] [CrossRef] [PubMed]
- Wang, S.Y.; Zhang, Y.J.; Chen, X.; Shi, X.C.; Herrera-Balandrano, D.D.; Liu, F.Q.; Laborda, P. Biocontrol methods for the management of Sclerotinia sclerotiorum in Legumes: A Review. Phytopathology 2024, 114, 1447–1457. [Google Scholar] [CrossRef]
- Zheng, Y.; Liu, T.; Wang, Z.; Wang, X.; Wang, H.; Li, Y.; Zheng, W.; Wei, S.; Leng, Y.; Li, J.; et al. Whole-genome sequencing and secondary metabolite exploration of the novel Bacillus velezensis BN with broad-spectrum antagonistic activity against fungal plant pathogens. Front. Microbiol. 2024, 15, 1498653. [Google Scholar] [CrossRef]
- Liu, F.; Chen, S.; Chen, X.; Yong, B.; He, B. Identification of chitinase from Bacillus velezensis strain S161 and its antifungal activity against Penicillium digitatum. Protein Expr. Purif. 2024, 223, 106562. [Google Scholar] [CrossRef]
- Poulaki, E.G.; Tjamos, S.E. Bacillus species: Factories of plant protective volatile organic compounds. J. Appl. Microbiol. 2023, 134, lxad037. [Google Scholar] [CrossRef] [PubMed]
- dos Santos, F.M.; de Souza Viera, L.; Camargo, D.P.; Queiroz dos Santos, D.K.; Brião Muniz, M.F.; Dressler da Costa, I.F.; Pereira Santos, J.R.; Pereira da Silva, J.C. Bacillus-based product protects soybean, improves grain yield and produces metabolites able to promote plant growth and antagonize pathogenic fungi. J. Phytopathol. 2024, 172, e13353. [Google Scholar] [CrossRef]
- Chebotar, V.K.; Gancheva, M.S.; Chizhevskaya, E.P.; Erofeeva, A.V.; Khiutti, A.V.; Lazarev, A.M.; Zhang, X.; Xue, J.; Yang, C.; Tikhonovich, I.A. Endophyte Bacillus vallismortis BL01 to control fungal and bacterial phytopathogens of tomato (Solanum lycopersicum L.) plants. Horticulturae 2024, 10, 1095. [Google Scholar] [CrossRef]
- Sharma, A.; Lee, H.J. Antimicrobial activity of probiotic bacteria isolated from plants: A Review. Foods 2025, 14, 495. [Google Scholar] [CrossRef]
- Penha, R.O.; Vandenberghe, L.P.S.; Faulds, C.; Soccol, V.T.; Soccol, C.R. Bacillus lipopeptides as powerful pest control agents for a more sustainable and healthy agriculture: Recent studies and innovations. Planta 2020, 251, 70. [Google Scholar] [CrossRef]
- Fira, D.; Dimkić, I.; Berić, T.; Lozo, J.; Stanković, S. Biological control of plant pathogens by Bacillus species. J. Biotechnol. 2018, 285, 44–55. [Google Scholar] [CrossRef]
- de Castro, M.T.; de Lima Ferreira, A.D.C.; do Nascimento, I.N.; Rocha, G.T.; Celestino, M.F.; Freire, Í.A.; Moreira, I.C.F.; Gomes, G.C.; dos Reis Cunha, B.B.; Montalvão, S.C.L.; et al. Endophytic Bacillus spp. of coffee plants (Coffea arabica L.) and its potential in the biocontrol of phytopathogenic fungi and Lepidoptera larvae. Egypt. J. Biol. Pest Control. 2025, 35, 8. [Google Scholar] [CrossRef]
- Zhang, W.; Mao, G.; Zhuang, J.; Yang, H. The co-inoculation of Pseudomonas chlororaphis H1 and Bacillus altitudinis Y1 promoted soybean [Glycine max (L.) Merrill] growth and increased the relative abundance of beneficial microorganisms in rhizosphere and root. Front. Microbiol. 2022, 13, 1079348. [Google Scholar] [CrossRef]
- Korir, H.; Mungai, N.W.; Thuita, M.; Hamba, Y.; Masso, C. Co-inoculation effect of Rhizobia and plant growth promoting Rhizobacteria on common bean growth in a low phosphorus soil. Front. Plant Sci. 2017, 8, 141. [Google Scholar] [CrossRef] [PubMed]
- Sibponkrung, S.; Kondo, T.; Tanaka, K.; Tittabutr, P.; Boonkerd, N.; Yoshida, K.I.; Teaumroong, N. Co-Inoculation of Bacillus velezensis strain S141 and Bradyrhizobium strains promotes nodule growth and nitrogen fixation. Microorganisms 2020, 8, 678. [Google Scholar] [CrossRef] [PubMed]
- Wang, J.; Zhao, S.; Xu, S.; Zhao, W.; Zhang, X.; Lei, Y.; Zhai, H.; Huang, Z. Co-inoculation of antagonistic Bacillus velezensis FH-1 and Brevundimonas diminuta NYM3 promotes rice growth by regulating the structure and nitrification function of rhizosphere microbiome. Front. Microbiol. 2023, 14, 1101773. [Google Scholar] [CrossRef]
- Nan, J.; Zhang, S.; Jiang, L. Antibacterial potential of Bacillus amyloliquefaciens GJ1 against citrus Huanglongbing. Plants 2021, 10, 261. [Google Scholar] [CrossRef]
- Yu, Y.Y.; Dou, G.X.; Sun, X.X.; Chen, L.; Zheng, Y.; Xiao, H.M.; Wang, Y.P.; Li, H.Y.; Guo, J.H.; Jiang, C.H. Transcriptome and biochemical analysis jointly reveal the effects of Bacillus cereus AR156 on postharvest strawberry gray mold and fruit quality. Front. Plant Sci. 2021, 12, 700446. [Google Scholar] [CrossRef]
- Ling, L.; Luo, H.; Yang, C.; Wang, Y.; Cheng, W.; Pang, M.; Jiang, K. Volatile organic compounds produced by Bacillus velezensis L1 as a potential biocontrol agent against postharvest diseases of wolfberry. Front. Microbiol. 2022, 13, 987844. [Google Scholar] [CrossRef]
- Wang, C.; Duan, T.; Shi, L.; Zhang, X.; Fan, W.; Wang, M.; Wang, J.; Ren, L.; Zhao, X.; Wang, Y. Characterization of volatile organic compounds produced by Bacillus siamensis YJ15 and their antifungal activity against Botrytis cinerea. Plant Dis. 2022, 106, 2321–2329. [Google Scholar] [CrossRef]
- Lyu, D.; Backer, R.; Berrué, F.; Martinez-Farina, C.; Hui, J.P.M.; Smith, D.L. Plant Growth-Promoting Rhizobacteria (PGPR) with microbial growth broth improve biomass and secondary metabolite accumulation of Cannabis sativa L. J. Agric. Food Chem. 2023, 71, 7268–7277. [Google Scholar] [CrossRef]
- Hashem, A.; Tabassum, B.; Fathi Abd Allah, E. Bacillus subtilis: A plant-growth promoting rhizobacterium that also impacts biotic stress. Saudi J. Biol. Sci. 2019, 26, 1291–1297. [Google Scholar] [CrossRef]
- Siddika, A.; Rashid, A.A.; Khan, S.N.; Khatun, A.; Karim, M.M.; Prasad, P.V.V.; Hasanuzzaman, M. Harnessing plant growth-promoting rhizobacteria, Bacillus subtilis and B. aryabhattai to combat salt stress in rice: A study on the regulation of antioxidant defense, ion homeostasis, and photosynthetic parameters. Front. Plant Sci. 2024, 15, 1419764. [Google Scholar] [CrossRef] [PubMed]
- Mashabela, M.D.; Tugizimana, F.; Steenkamp, P.A.; Piater, L.A.; Dubery, I.A.; Mhlongo, M.I. Untargeted metabolite profiling to elucidate rhizosphere and leaf metabolome changes of wheat cultivars (Triticum aestivum L.) treated with the plant growth-promoting rhizobacteria Paenibacillus alvei (T22) and Bacillus subtilis. Front. Microbiol. 2022, 13, 971836. [Google Scholar] [CrossRef] [PubMed]
- Comtet-Marre, S.; Chakoory, O.; Peyret, P. Targeted 16S rRNA Gene Capture by Hybridization and bioinformatic analysis. Methods Mol. Biol. 2023, 2605, 187–208. [Google Scholar] [CrossRef]
- Kumar, S.; Stecher, G.; Tamura, K. MEGA7: Molecular evolutionary genetics analysis version 7.0 for bigger datasets. Mol. Biol. Evol. 2016, 33, 1870–1874. [Google Scholar] [CrossRef]
- Schneider, C.A.; Rasband, W.S.; Eliceiri, K.W. NIH Image to ImageJ: 25 years of image analysis. Nat. Methods 2012, 9, 671–675. [Google Scholar] [CrossRef]
- El-Saadony, M.T.; Saad, A.M.; Soliman, S.M.; Salem, H.M.; Ahmed, A.I.; Mahmood, M.; El-Tahan, A.M.; Ebrahim, A.A.M.; Abd El-Mageed, T.A.; Negm, S.H.; et al. Plant growth-promoting microorganisms as biocontrol agents of plant diseases: Mechanisms, challenges and future perspectives. Front. Plant Sci. 2022, 13, 923880. [Google Scholar] [CrossRef]
- Ayaz, M.; Li, C.H.; Ali, Q.; Zhao, W.; Chi, Y.K.; Shafiq, M.; Ali, F.; Yu, X.Y.; Yu, Q.; Zhao, J.T.; et al. Bacterial and fungal biocontrol agents for plant disease protection: Journey from lab to field, current status, challenges, and global perspectives. Molecules 2023, 28, 6735. [Google Scholar] [CrossRef]
- Sorokan, A.; Gabdrakhmanova, V.; Kuramshina, Z.; Khairullin, R.; Maksimov, I. Plant-Associated Bacillus thuringiensis and Bacillus cereus: Inside agents for biocontrol and genetic recombination in phytomicrobiome. Plants 2023, 12, 4037. [Google Scholar] [CrossRef]
- Keshmirshekan, A.; de Souza Mesquita, L.M.; Ventura, S.P.M. Biocontrol manufacturing and agricultural applications of Bacillus velezensis. Trends Biotechnol. 2024, 42, 986–1001. [Google Scholar] [CrossRef]
- Ma, S.; Wang, Y.; Teng, W. Bacillus velezensis K-9 as a potential biocontrol agent for managing potato scab. Plant Dis. 2023, 107, 3943–3951. [Google Scholar] [CrossRef]
- Li, Y.; Héloir, M.C.; Zhang, X.; Geissler, M.; Trouvelot, S.; Jacquens, L.; Henkel, M.; Su, X.; Fang, X.; Wang, Q.; et al. Surfactin and fengycin contribute to the protection of a Bacillus subtilis strain against grape downy mildew by both direct effect and defence stimulation. Mol. Plant Pathol. 2019, 20, 1037–1050. [Google Scholar] [CrossRef] [PubMed]
- Mandal, S.M.; Barbosa, A.E.; Franco, O.L. Lipopeptides in microbial infection control: Scope and reality for industry. Biotechnol. Adv. 2013, 31, 338–345. [Google Scholar] [CrossRef] [PubMed]
- Yan, L.; Li, G.; Liang, Y.; Tan, M.; Fang, J.; Peng, J.; Li, K. Co-production of surfactin and fengycin by Bacillus subtilis BBW1542 isolated from marine sediment: A promising biocontrol agent against foodborne pathogens. J. Food Sci. Technol. 2024, 61, 563–572. [Google Scholar] [CrossRef]
- Luo, L.; Zhao, C.; Wang, E.; Raza, A.; Yin, C. Bacillus amyloliquefaciens as an excellent agent for biofertilizer and biocontrol in agriculture: An overview for its mechanisms. Microbiol. Res. 2022, 259, 127016. [Google Scholar] [CrossRef] [PubMed]
- WoldemariamYohannes, K.; Wan, Z.; Yu, Q.; Li, H.; Wei, X.; Liu, Y.; Wang, J.; Sun, B. Prebiotic, Probiotic, Antimicrobial, and functional food applications of Bacillus amyloliquefaciens. J. Agric. Food Chem. 2020, 68, 14709–14727. [Google Scholar] [CrossRef]
- Panchami, P.S.; Geetha Thanuja, K.; Karthikeyan, S. Isolation and characterization of indigenous Plant Growth-Promoting Rhizobacteria (PGPR) from Cardamom Rhizosphere. Curr. Microbiol. 2020, 77, 2963–2981. [Google Scholar] [CrossRef]
- Galindo, F.S.; Thiengo, C.C.; Pagliari, P.H.; Bernardes, J.V.S.; Dos Santos, G.D.; Longato, P.A.F.; Vilela, L.S.; Teixeira Filho, M.C.M.; Lavres, J. Synergism of Bacillus subtilis and Azospirillum brasilense for enhanced N-use efficiency and maize growth: Evidence from (15)N isotopic and physiological responses. Physiol. Plant. 2025, 177, e70205. [Google Scholar] [CrossRef]
- Sun, B.; Bai, Z.; Bao, L.; Xue, L.; Zhang, S.; Wei, Y.; Zhang, Z.; Zhuang, G.; Zhuang, X. Bacillus subtilis biofertilizer mitigating agricultural ammonia emission and shifting soil nitrogen cycling microbiomes. Environ. Int. 2020, 144, 105989. [Google Scholar] [CrossRef]
- Gu, S.; Wei, Z.; Shao, Z.; Friman, V.P.; Cao, K.; Yang, T.; Kramer, J.; Wang, X.; Li, M.; Mei, X.; et al. Competition for iron drives phytopathogen control by natural rhizosphere microbiomes. Nat. Microbiol. 2020, 5, 1002–1010. [Google Scholar] [CrossRef]
- Harrison, F.; Paul, J.; Massey, R.C.; Buckling, A. Interspecific competition and siderophore-mediated cooperation in Pseudomonas aeruginosa. ISME J. 2008, 2, 49–55. [Google Scholar] [CrossRef] [PubMed]
- Dhar, S.K.; Kaur, J.; Singh, G.B.; Chauhan, A.; Tamang, J.; Lakhara, N.; Asyakina, L.; Atuchin, V.; Mudgal, G.; Abdi, G. Novel Bacillus and Prestia isolates from Dwarf century plant enhance crop yield and salinity tolerance. Sci. Rep. 2024, 14, 14645. [Google Scholar] [CrossRef] [PubMed]
- Puan, S.L.; Erriah, P.; Baharudin, M.M.A.; Yahaya, N.M.; Kamil, W.; Ali, M.S.M.; Ahmad, S.A.; Oslan, S.N.; Lim, S.; Sabri, S. Antimicrobial peptides from Bacillus spp. and strategies to enhance their yield. Appl. Microbiol. Biotechnol. 2023, 107, 5569–5593. [Google Scholar] [CrossRef] [PubMed]
- González Pereyra, M.L.; Di Giacomo, A.L.; Lara, A.L.; Martínez, M.P.; Cavaglieri, L. Aflatoxin-degrading Bacillus sp. strains degrade zearalenone and produce proteases, amylases and cellulases of agro-industrial interest. Toxicon Off. J. Int. Soc. Toxinology 2020, 180, 43–48. [Google Scholar] [CrossRef]
- Li, B.; Duan, J.; Ren, J.; Francis, F.; Li, G. Isolation and characterization of two new deoxynivalenol-degrading strains, Bacillus sp. HN117 and Bacillus sp. N22. Toxins 2022, 14, 781. [Google Scholar] [CrossRef]

| Compounds | m/z | Formula | DXQ-1 Fold Change |
|---|---|---|---|
| Leu-Pro | 273.14 | C11 H20 N2 O3 | 425.71 |
| LPE 15:0 | 438.26 | C20 H42 N O7 P | 161.67 |
| 4′-ethyl-N-(1-ethynylcyclohexyl)[1,1′-biphenyl]-4-carboxamide | 330.19 | C23 H25 N O | 135.95 |
| LPG 15:0 | 469.25 | C21 H43 O9 P | 111.09 |
| Propionyl-L-carnitine | 216.12 | C10 H19 N O4 | 98.36 |
| 1,1-Dimethyl-2-oxopropyl N-[2-(2-pyridyl)ethyl]carbamate | 251.13 | C13 H18 N2 O3 | 97.11 |
| Esculin | 339.07 | C15 H16 O9 | 90.19 |
| Lauric Acid | 245.17 | C12 H24 O2 | 89.65 |
| Tanespimycin | 566.28 | C31 H43 N3 O8 | 83.86 |
| 2,3-Dinor prostaglandin E1 | 307.19 | C18 H30 O5 | 64.45 |
Disclaimer/Publisher’s Note: The statements, opinions and data contained in all publications are solely those of the individual author(s) and contributor(s) and not of MDPI and/or the editor(s). MDPI and/or the editor(s) disclaim responsibility for any injury to people or property resulting from any ideas, methods, instructions or products referred to in the content. |
© 2025 by the authors. Licensee MDPI, Basel, Switzerland. This article is an open access article distributed under the terms and conditions of the Creative Commons Attribution (CC BY) license (https://creativecommons.org/licenses/by/4.0/).
Share and Cite
Xu, Q.; Shan, Z.; Yang, Z.; Ma, H.; Zou, L.; Dong, M.; Qi, T. Biocontrol Potential of Bacillus stercoris Strain DXQ-1 Against Rice Blast Fungus Guy11. Microorganisms 2025, 13, 1538. https://doi.org/10.3390/microorganisms13071538
Xu Q, Shan Z, Yang Z, Ma H, Zou L, Dong M, Qi T. Biocontrol Potential of Bacillus stercoris Strain DXQ-1 Against Rice Blast Fungus Guy11. Microorganisms. 2025; 13(7):1538. https://doi.org/10.3390/microorganisms13071538
Chicago/Turabian StyleXu, Qian, Zhengli Shan, Zhihao Yang, Haoyu Ma, Lijuan Zou, Ming Dong, and Tuo Qi. 2025. "Biocontrol Potential of Bacillus stercoris Strain DXQ-1 Against Rice Blast Fungus Guy11" Microorganisms 13, no. 7: 1538. https://doi.org/10.3390/microorganisms13071538
APA StyleXu, Q., Shan, Z., Yang, Z., Ma, H., Zou, L., Dong, M., & Qi, T. (2025). Biocontrol Potential of Bacillus stercoris Strain DXQ-1 Against Rice Blast Fungus Guy11. Microorganisms, 13(7), 1538. https://doi.org/10.3390/microorganisms13071538

